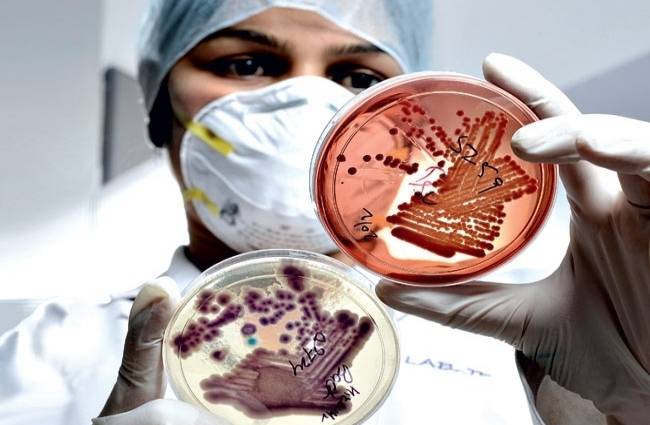

चार साल में देश के 11 परमाणु वैज्ञानिकों की रहस्यमय मौत
परमाणु ऊर्जा विभाग द्वारा मुहैया कराए गए ताजा आंकड़ों के मुताबिक देश में 2009 से 2013 के बीच 11 परमाणु वैज्ञानिकों की अप्राकृतिक मौत के मामले सामने आए. विभाग की प्रयोगशालाओं और अनुसंधान केंद्रों में कार्यरत आठ वैज्ञानिकों और इंजीनियरों की विस्फोट में या समुद्र में डूबने से या फांसी पर लटकने से मौत हो गई.
Advertisement
X

परमाणु ऊर्जा विभाग द्वारा मुहैया कराए गए ताजा आंकड़ों के मुताबिक देश में 2009 से 2013 के बीच 11 परमाणु वैज्ञानिकों की अप्राकृतिक मौत के मामले सामने आए. विभाग की प्रयोगशालाओं और अनुसंधान केंद्रों में कार्यरत आठ वैज्ञानिकों और इंजीनियरों की विस्फोट में या समुद्र में डूबने से या फांसी पर लटकने से मौत हो गई.
के रहने वाले राहुल सेहरावत के 21 सितंबर के आरटीआई आवेदन के जवाब में विभाग ने बताया कि परमाणु ऊर्जा निगम के भी तीन अधिकारियों की इस अवधि में रहस्यमयी परिस्थितियों में मौत हो गई, जिनमें से दो ने कथित तौर पर खुदकुशी कर ली थी और एक की सड़क दुर्घटना में मौत हो गई.
बार्क, ट्रांबे में कार्यरत सी-समूह के दो के शव 2010 में उनके घरों पर लटके हुए मिले थे, वहीं रावतभाटा में इसी दर्जे का एक वैज्ञानिक 2012 में अपने आवास पर मृत मिला. बार्क के एक मामले में पुलिस का दावा है कि उन्होंने लंबी बीमारी की वजह से खुदकुशी कर ली और मामला बंद कर दिया गया, वहीं बाकी मामलों में अब भी जांच चल रही है.
बार्क, ट्रांबे की रसायन विज्ञान की प्रयोगशाला में 2010 में दो शोधार्थियों की रहस्यमयी तरीके से लगी आग में मृत्यु हो गई थी. एफ-ग्रेड के एक वैज्ञानिक की मुंबई में उनके आवास पर हत्या कर दी गई. संदेह है कि उनकी गला दबाकर की गई, लेकिन अभी तक आरोपी का पता नहीं चला है.
Advertisement
आरआरसीएटी के डी-ग्रेड के एक वैज्ञानिक ने भी कथित तौर पर खुदकुशी कर ली थी, जिसके बाद पुलिस ने मामले को बंद कर दिया. कलपक्कम में कार्यरत एक और वैज्ञानिक ने 2013 में कथित तौर पर समुद्र में कूदकर गंवा दी थी.
मुंबई के एक वैज्ञानिक ने कथित तौर पर फांसी पर लटक कर खुदकुशी कर ली थी, जिसके लिए पुलिस निजी कारणों को जिम्मेदार बता रही है. एक वैज्ञानिक ने कथित तौर पर कर्नाटक के करवर में काली नदी में कूदकर जान दे दी थी. ने इसके पीछे भी निजी वजह बताई है.
इनपुट- भाषा